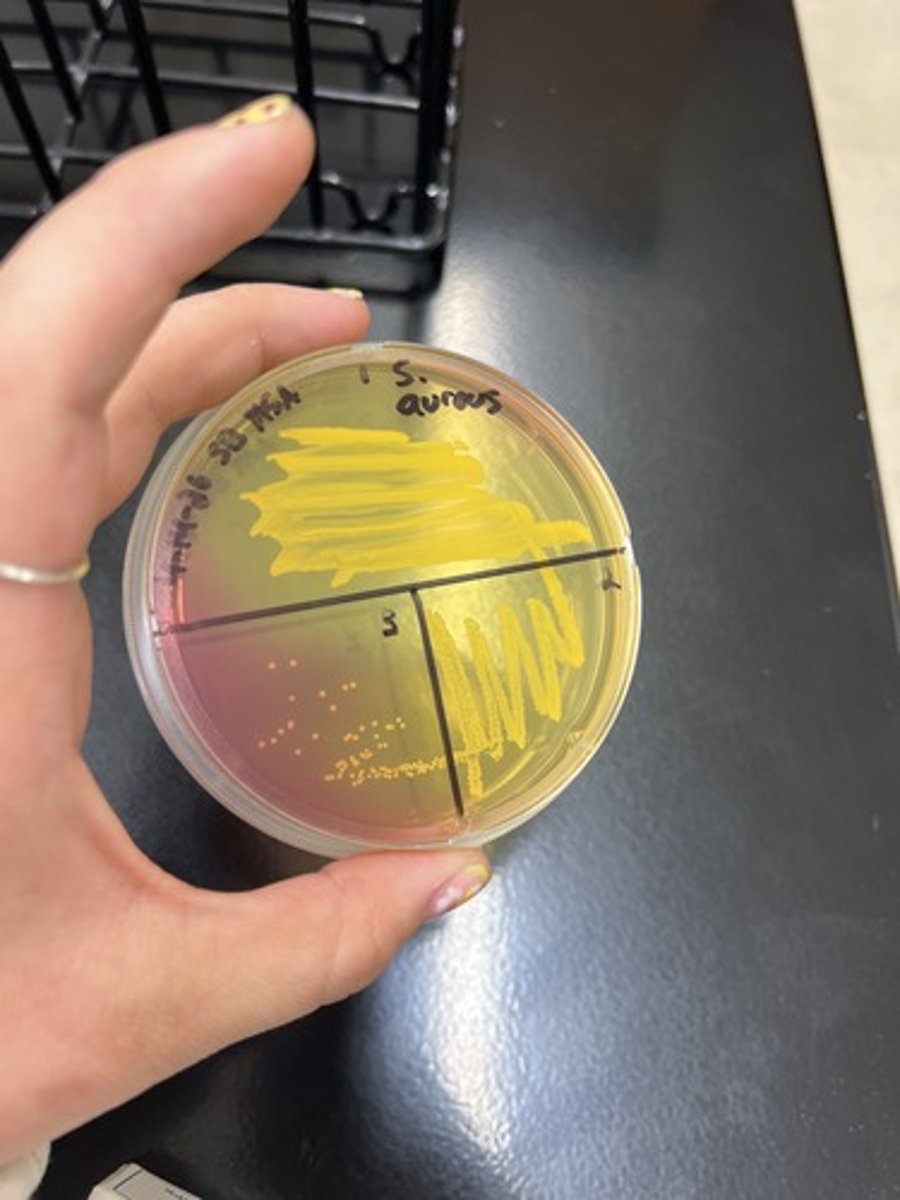
<p><strong>Selective </strong>for Halotolerant Organisms</p><p><strong>Differential </strong>for Mannitol fermentation</p><p>Fermentative (+): Yellow Agar</p>
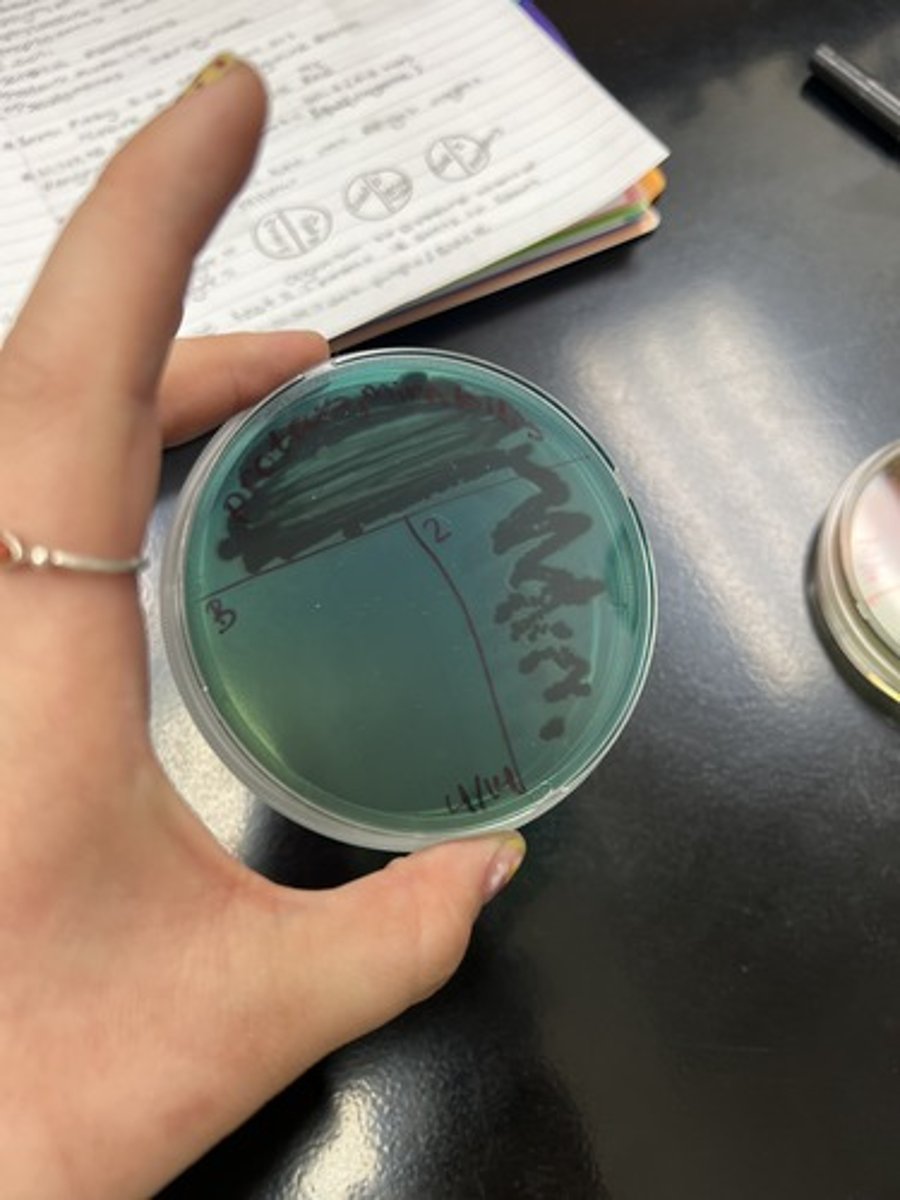
<p><strong>Selective </strong>for Gram (-) sp.</p><p><strong>Differential </strong>for Lactose, Sucrose, &amp; Salicin</p><p>Neutral: Blue/ Green</p>
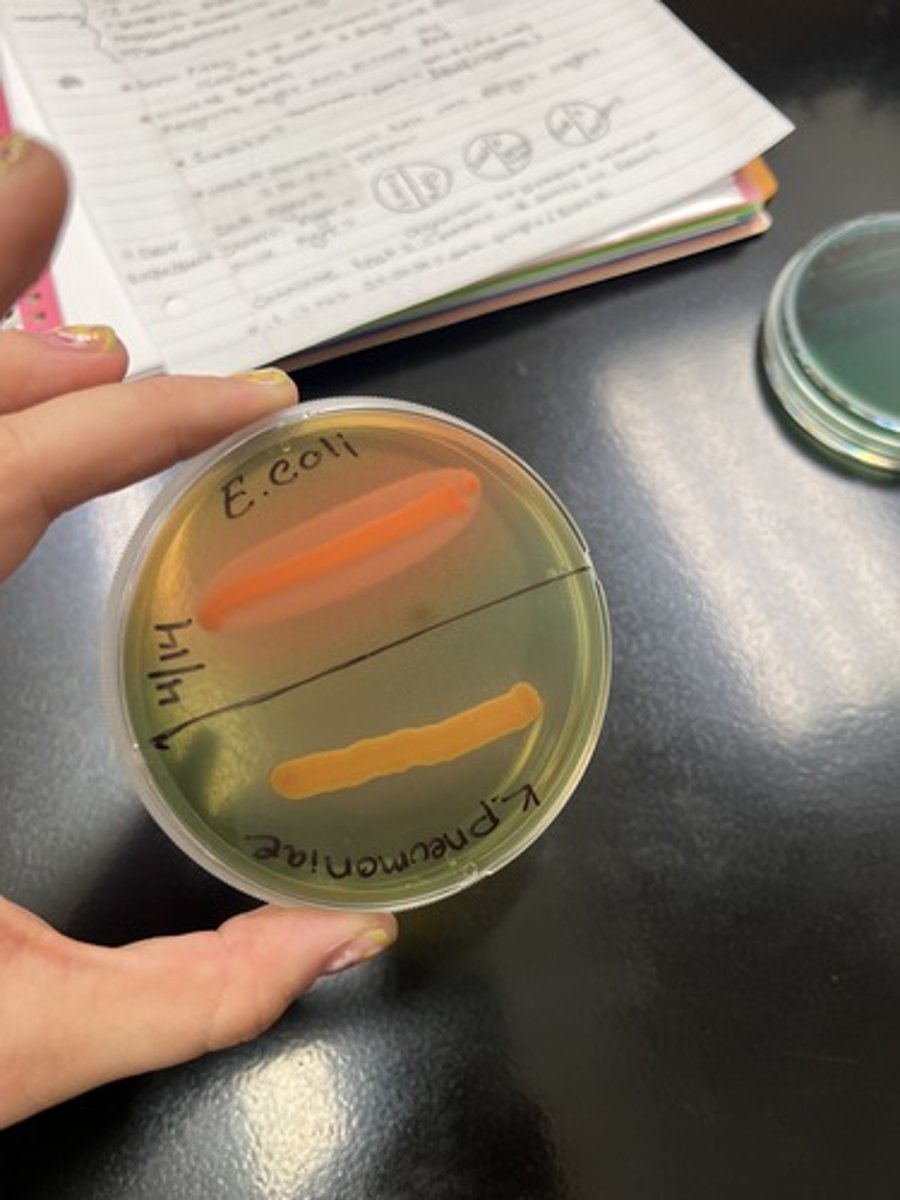
<p><strong>Selective </strong>for Gram (-) sp.</p><p><strong>Differential </strong>for Lactose, Sucrose, &amp; Salicin Fermentation (+): Yellow/ Orange,</p>
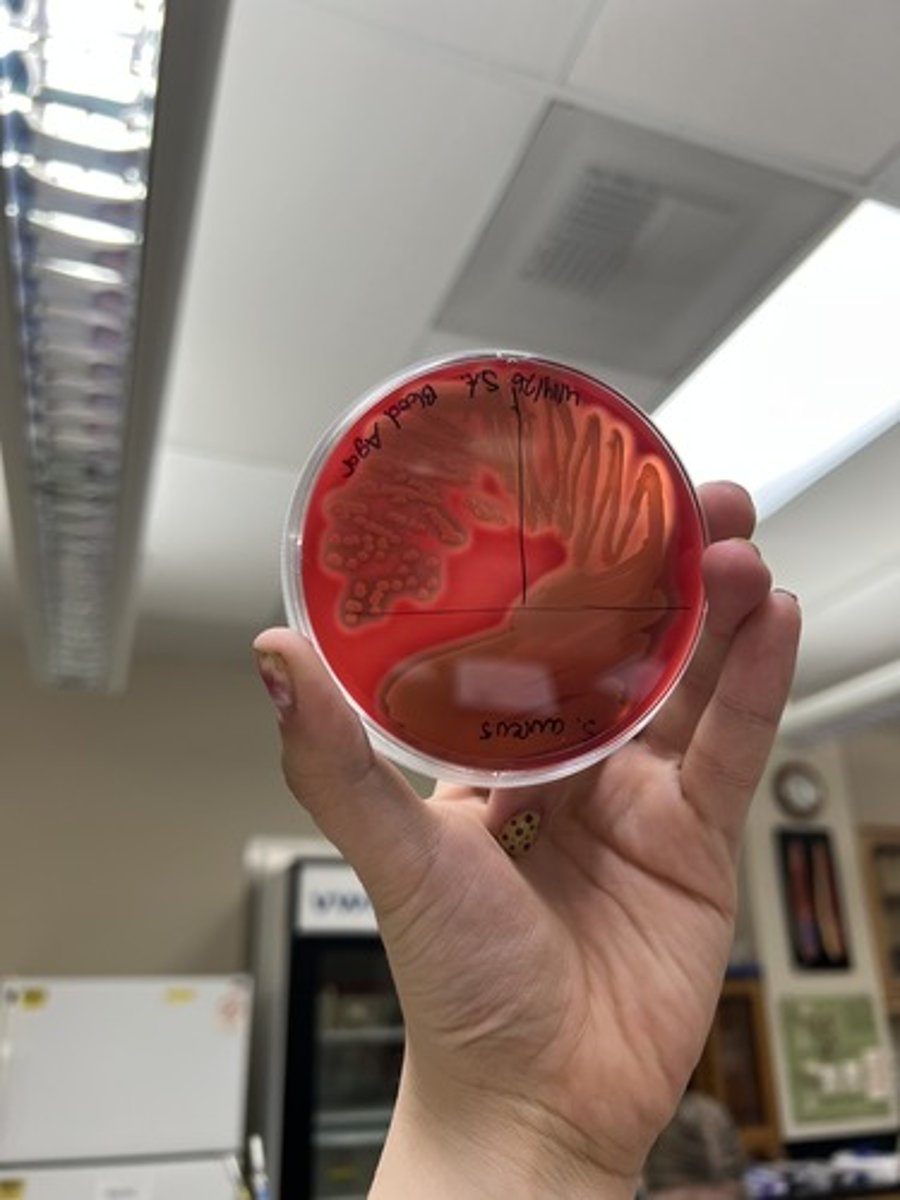
<p><strong>Differential </strong>for hemolysis of red blood cells</p><p>Alpha (α, partial lysis, green/brown)- hemolysis (Beta: full lysis, clear halo, Gamma: no lysis)</p>
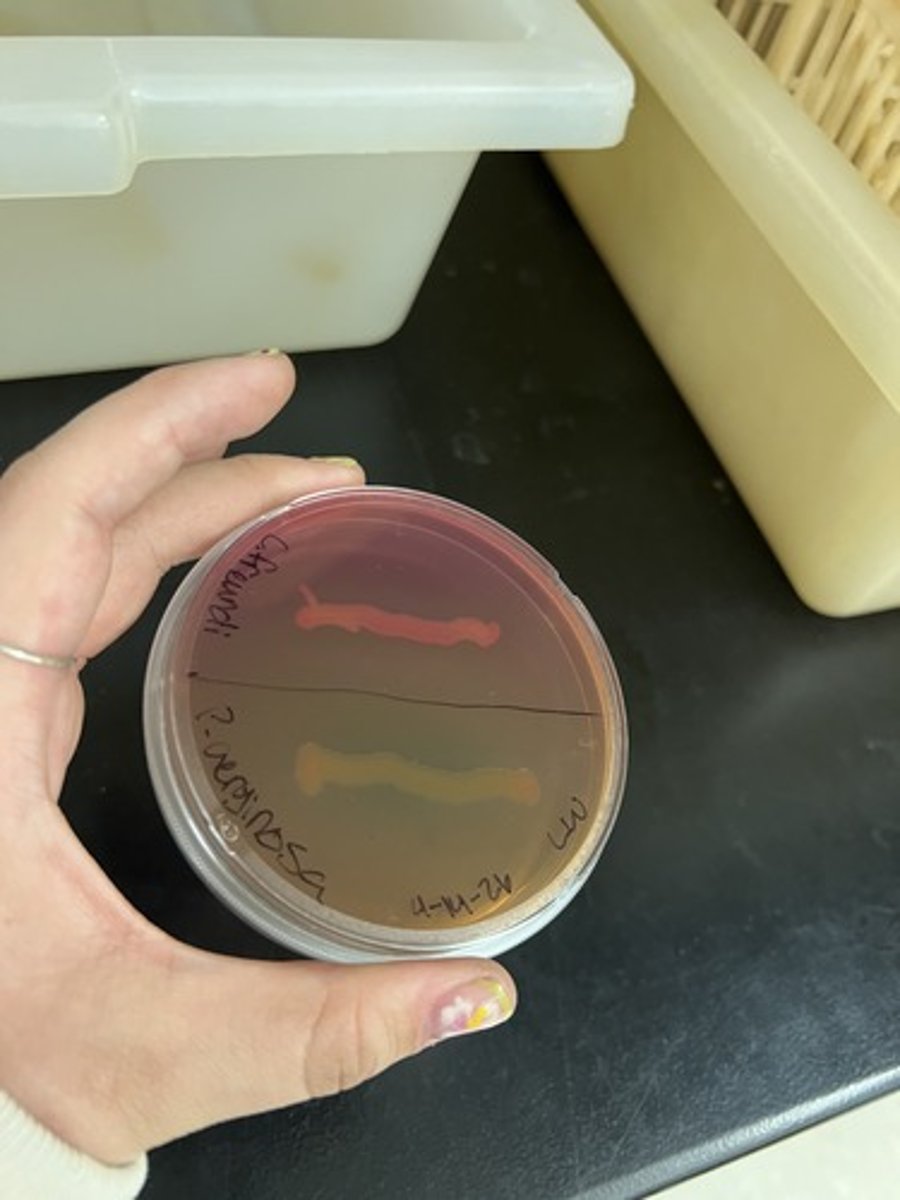
<p><strong>Selective </strong>for gram (-) sp.</p><p><strong>Differential </strong>for lactose fermentation</p><p>Fermentation (+): Pink Colonies</p><p>Beige agar (-): Peptone Utilization</p><p>EX: <em>Escherichia coli</em></p>
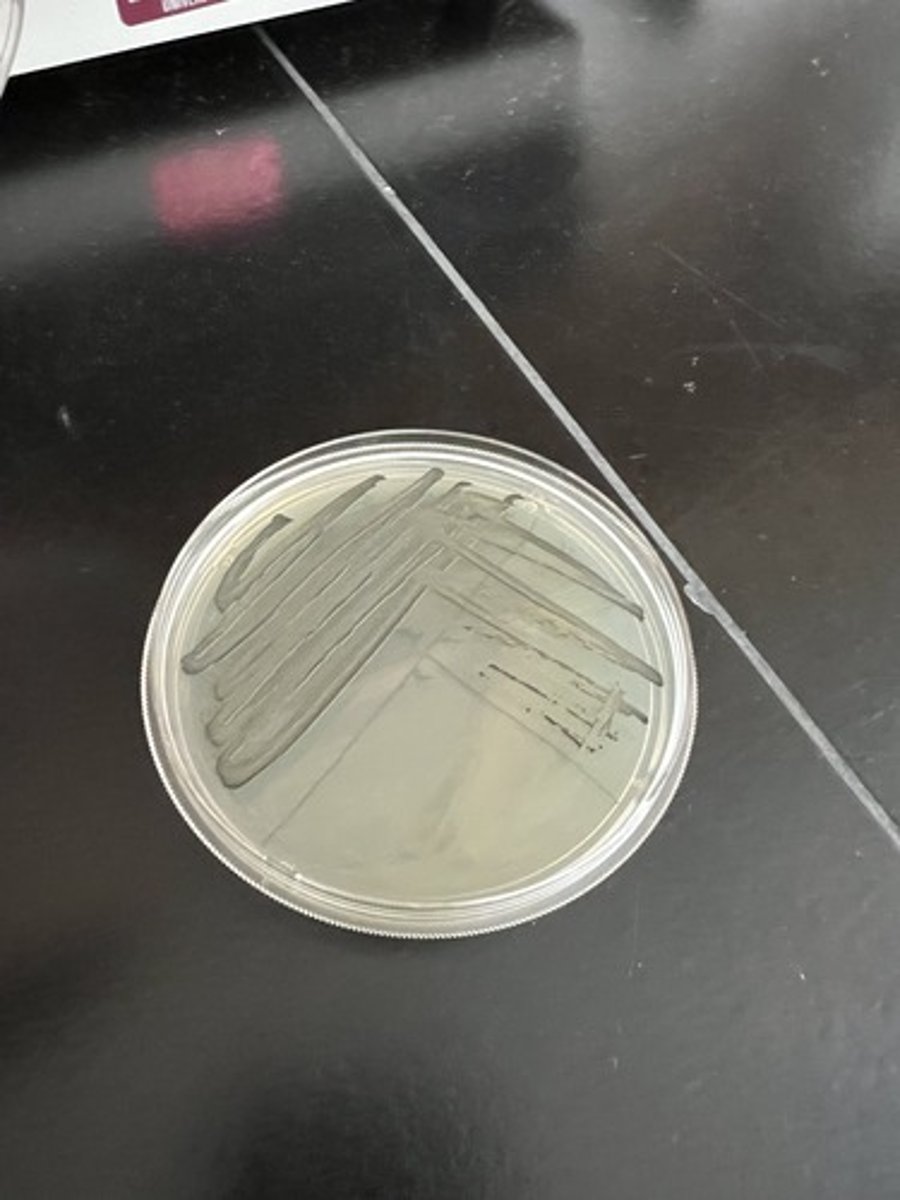
<p><strong>Differential </strong>for organisms ability to reduce Tellurite → Tellurium</p><p>Gram (+) sp. prefer this medium!</p>
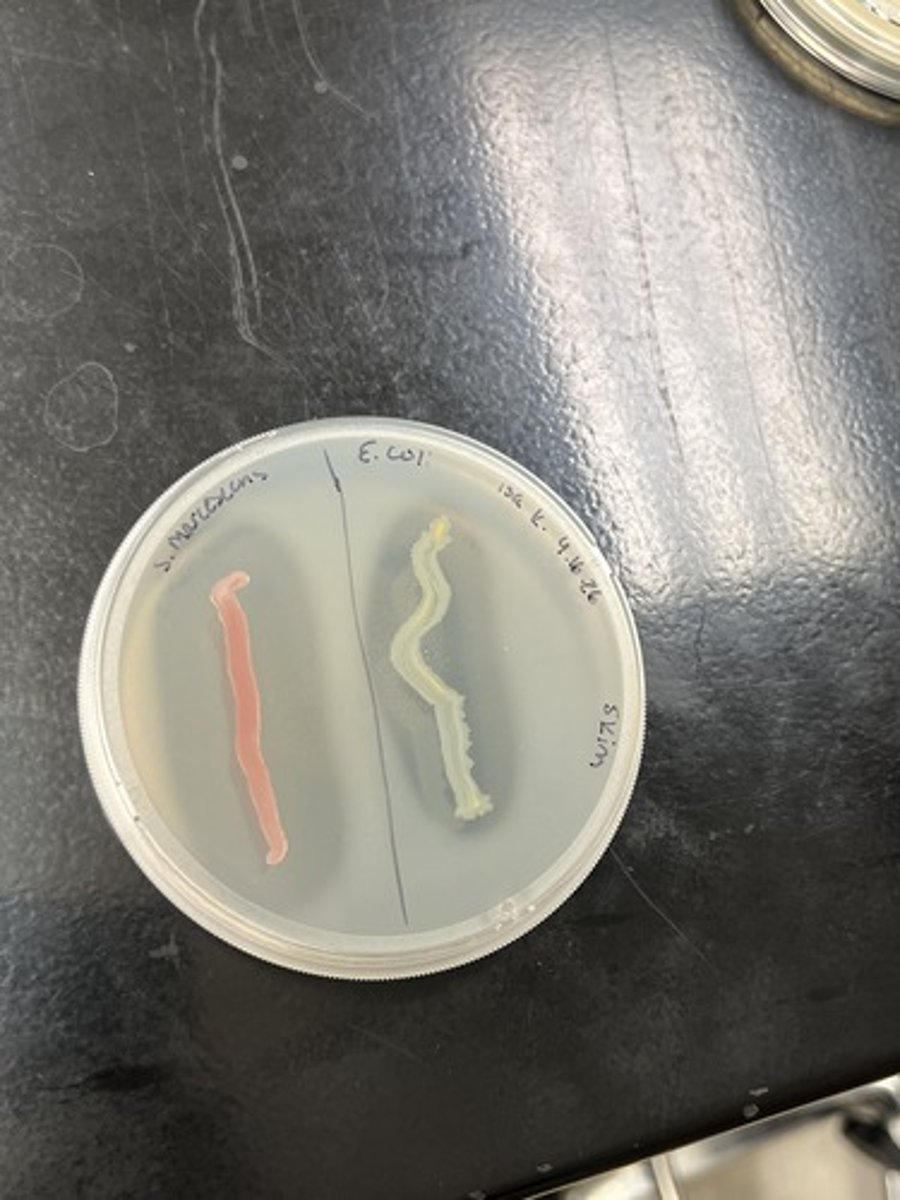
<p>Tests for organisms ability to use casienase to break down casein.</p><p>Casein hydrolysis (+) - Clearing around organism</p>
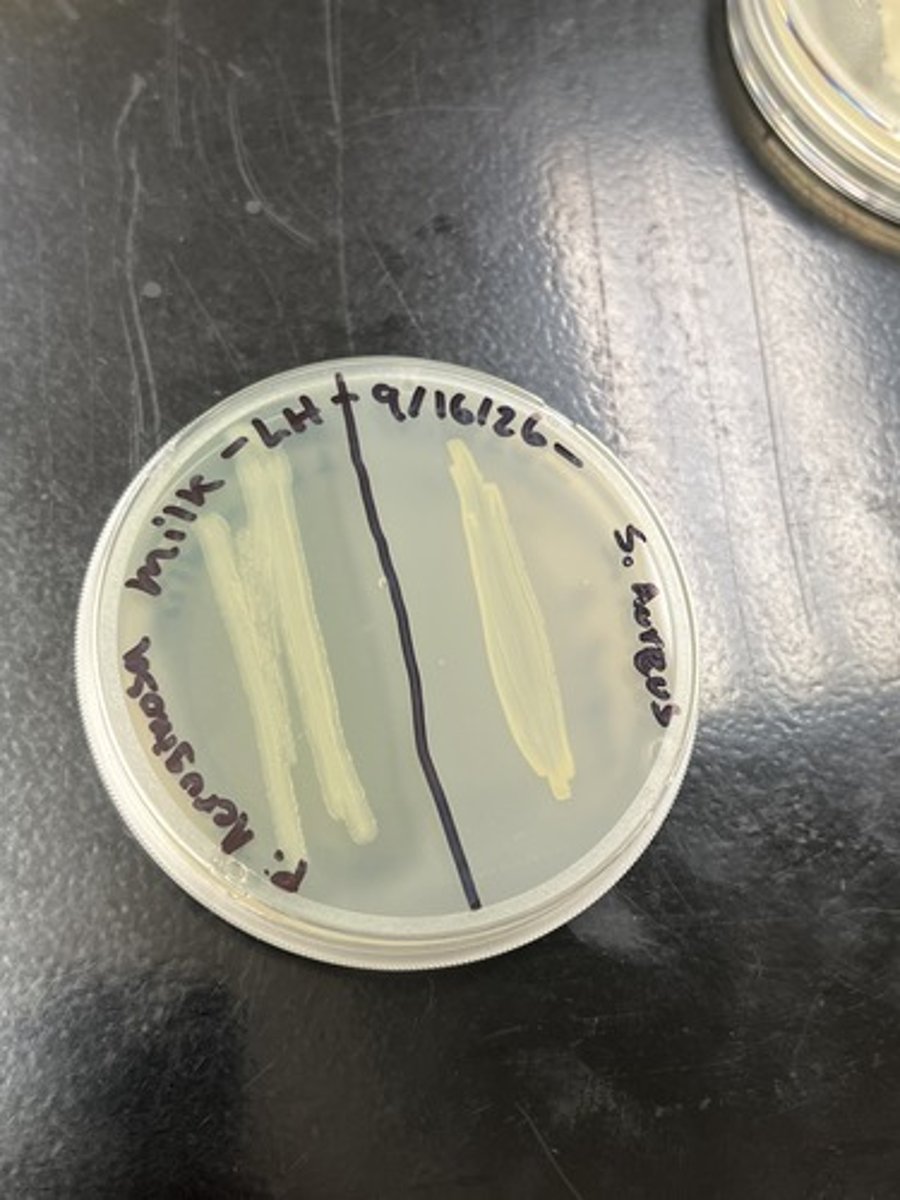
<p>Tests for organisms ability to use casienase to break down casein.</p><p>Inability for casein hydrolysis (-) - No clearing</p>
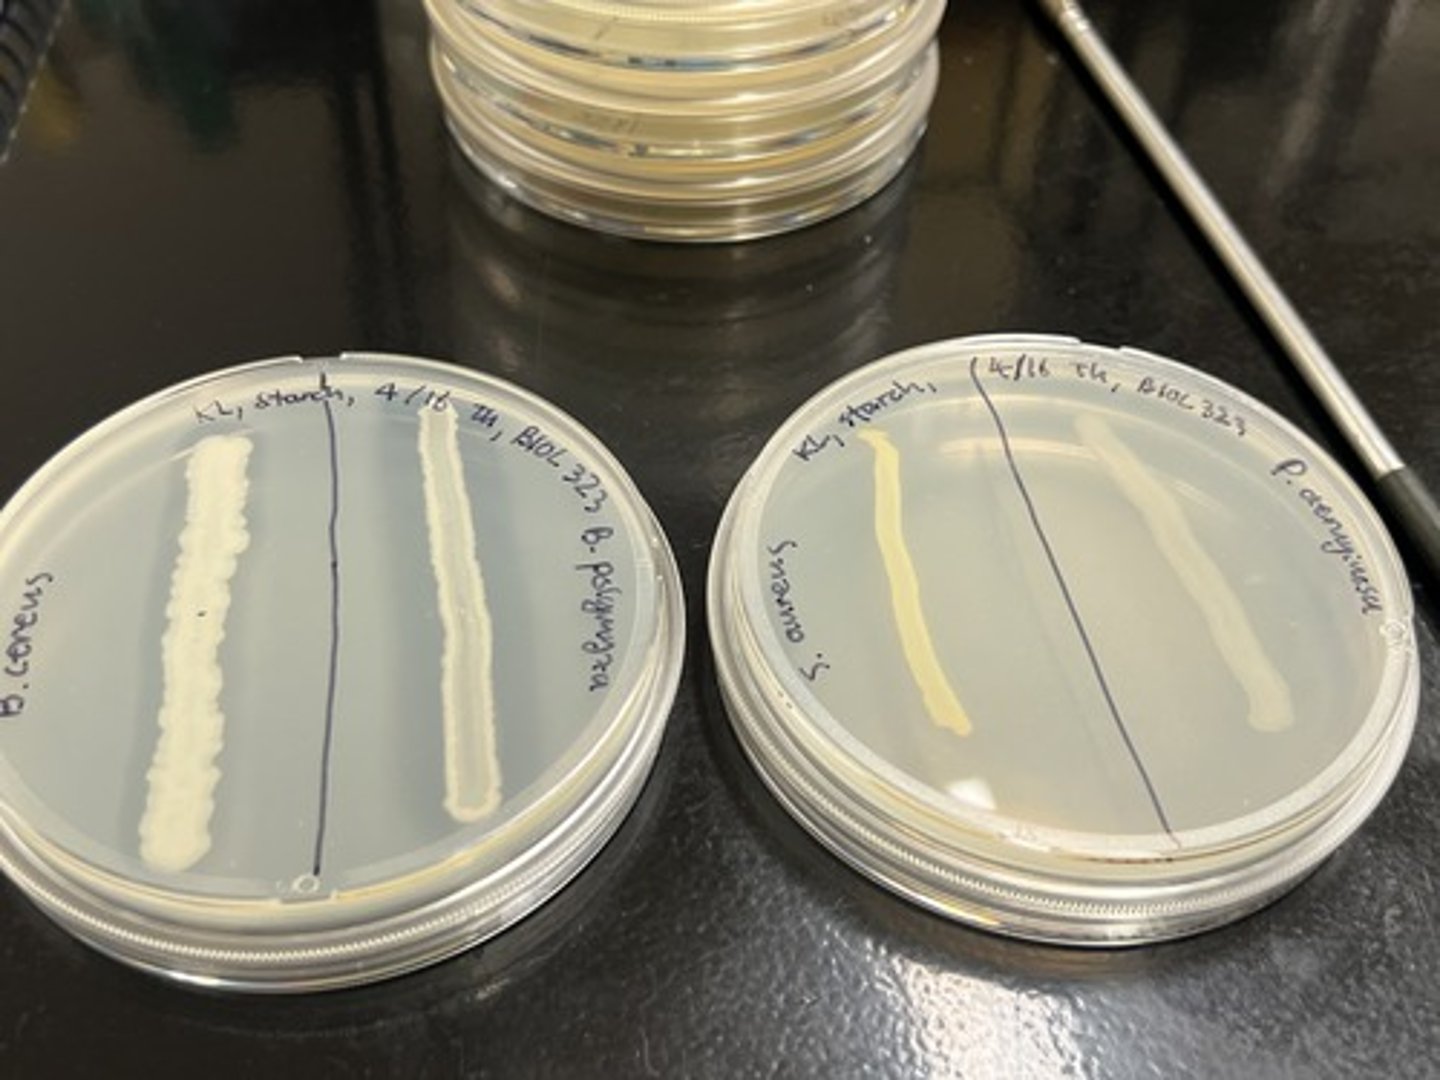
<p>Tests for organisms ability to breakdown starch via the amylase enzyme.</p><p>Ability to use amylase to breakdown starch (+) - Clearing of organism</p>
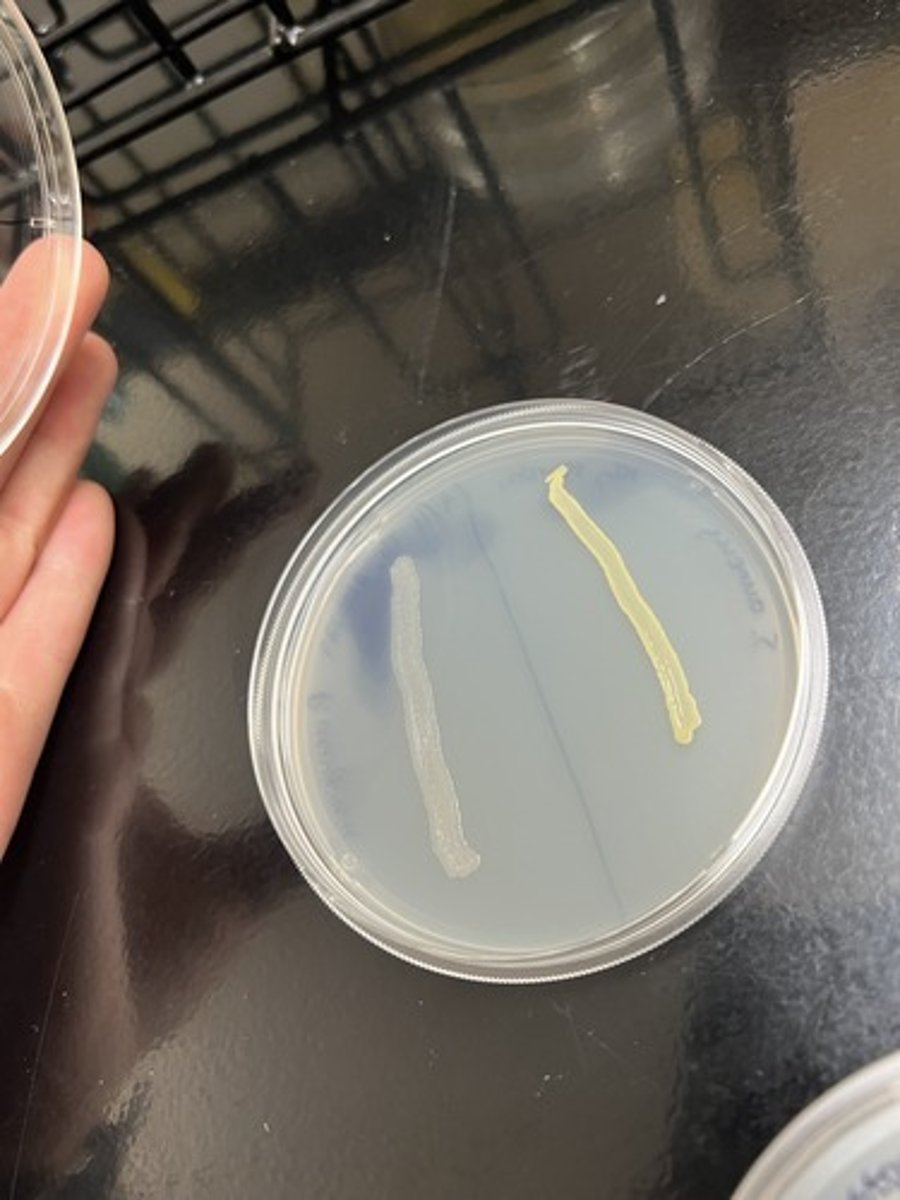
<p><strong>Differentiates </strong>organisms based on the ability to produce the DNase enzyme.</p><p>Ability to produce DNase (+) - Clearing around organism</p>

1/37
Looks like no tags are added yet.
Name | Mastery | Learn | Test | Matching | Spaced | Call with Kai |
|---|
No analytics yet
Send a link to your students to track their progress
Mannitol Salt Agar
Selective for Halotolerant Organisms
Differential for Mannitol fermentation
Fermentative (+): Yellow Agar
Negative Hektoen Enteric Agar
Selective for Gram (-) sp.
Differential for Lactose, Sucrose, & Salicin
Neutral: Blue/ Green
Positive Hektoen Enteric Agar
Selective for Gram (-) sp.
Differential for Lactose, Sucrose, & Salicin Fermentation (+): Yellow/ Orange,
Blood Agar
Differential for hemolysis of red blood cells
Alpha (α, partial lysis, green/brown)- hemolysis (Beta: full lysis, clear halo, Gamma: no lysis)
MacConkey Agar
Selective for gram (-) sp.
Differential for lactose fermentation
Fermentation (+): Pink Colonies
Beige agar (-): Peptone Utilization
EX: Escherichia coli
Tellurite Agar
Differential for organisms ability to reduce Tellurite → Tellurium
Gram (+) sp. prefer this medium!
Milk Agar
Tests for organisms ability to use casienase to break down casein.
Casein hydrolysis (+) - Clearing around organism
Skim Milk Agar
Tests for organisms ability to use casienase to break down casein.
Inability for casein hydrolysis (-) - No clearing
Starch Agar
Tests for organisms ability to breakdown starch via the amylase enzyme.
Ability to use amylase to breakdown starch (+) - Clearing of organism
DNase Agar
Differentiates organisms based on the ability to produce the DNase enzyme.
Ability to produce DNase (+) - Clearing around organism
Sugar Fermentation Broth
Tests for organism's ability to ferment sugars (i.e., Glucose or Lactose).
Fermentative sp. (+) - Yellow broth

Urea Broth
Tests for organisms ability to use Urease enzyme to hydrolyze.
Positive test: Magenta broth

Arginine Dihydrolase Medium
Tests for the presence of the Arginine Dihydrolase enzyme.
Positive test: Broth turns purple

Lysine Decarboxylase Medium
Differentiates sp. based on their ability to make the Lysine Decarboxylase enzyme.
Production of enzyme (+): Purple broth
No enzyme production (-) test: Yellow broth

Negative Gelatinase Medium
Tests for organisms ability to produce gelatinase to hydrolyze gelatin.
Negative test- Solid medium

Positive Gelatinase Medium
Tests for organisms ability to produce gelatinase to hydrolyze gelatin.
Positive test (+) - Liquid medium

Nitrate Broth
Tests organisms ability to reduce Nitrate to Nitrite (or Nitrogen/ Ammonia).
Reagents: Sulfanilic Acid + α-naphylamine / Zinc for negative Rxn's (colorless after addition of reagents).

Nitrate Broth w/o addition of Zinc: Red
Organism is able to reduce Nitrate to Nitrite.

Nitrate Broth w/ addition of Zinc: Colorless
Reduction of Nitrate to Nitrogen or Ammonia (N2 or NH3)

Nitrate Broth w/ addition of Zinc: Red
Zinc reduces Nitrate NOT the organism.

Positive Catalase test
Microorganism produces catalase enzyme - bubbles form
Negative catalase test
Microorganism does not produce catalase enzyme - no bubbles
Positive oxidase test
Redox gas reduces cytochrome c oxidase - colorless dye turns dark purple
Negative oxidase test
Redox gas does not reduce cytochrome c oxidase - colorless dye remains
Crystal violet is removed after 95% EtOH rinse
Gram (-)
Peptidoglycan layer shrinks and dehydrates, retaining crystal violet/grams iodine complex
Gram (+)
Positive acid fast stain
Carbol fuchsin binds to mycolic-acid - fuchsia color
Negative acid fast stain
Deep blue - mycolic-acid is not present
Positive string test
Gram (-)
Potassium hydroxide breaks down cell walls and releases chromosomal material
Bacterial suspension becomes thick and sticky
Safranin counter stain
Stains both pink
Gram (+): crystal violet + pink = purple
Gram (-): pink
Crystal violet
Stains both purple
Entangles with peptidoglycan layer
Capsule staining - Congo Red
Stains proteins in the background of the cells
Hektoen enteric agar enzyme
Thiosulfate reductase
Gram (-) cell walls
Double phospholipid bilayer surrounding thin peptidoglycan layer
Endospores
Some bacteria grown them - they protect vegetative DNA from extreme environments
Acid fast staining - Methylene Blue
Carbol fuchsin stains bright red, blue stain provides contrast between (+) and (-)
Grams iodine in gram staining
Forms complex w/ crystal violet in peptidoglycan layer
ONLY GRAM (+)
Halotolerant organisms
Capable of surviving and growing in high-salt environments but don’t require them
EX: Bacillus cereus